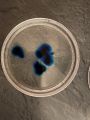
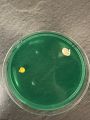
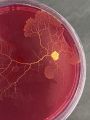
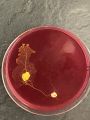
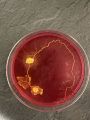
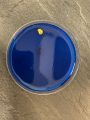
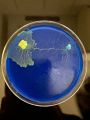
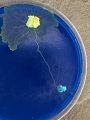
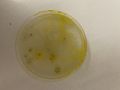
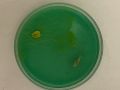
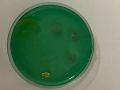
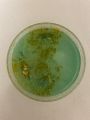
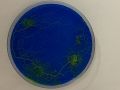
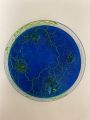
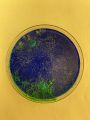
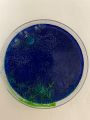

Project
Growth and Discovery
Through development we grow. Through discovery we grow.
We start as an infant and we travel our way through life building and growing as we go. We discover new landscapes and environments, and we navigate our way through the challenges, and we overcome these obstacles. We adapt to different spaces and we continue to grow. What are we? One may think we are the species of humankind. We share many behavioural characteristics with humankind, but we are not. We are Physarum polycephalum a species of slime mould. And to grow we discover, and to discover we grow. Through this methodology we succeed, and you can join us through this process of discovery.
As I discover I advance
Documentation
This Wiki page explores my weekly process, the layout shows my week by week process that the viewer can read and look through in order to understand my development .
My project this semester started with a fascination towards Nematodes and their movement abilities. Through exploring this research I discovered that Nematodes eat each other and I became fascinated whether they would eat their offspring. While following this research direction I tried to cultivate Nematodes so that I could begin to work and experiment with them hands on and physically. Unfortunately this was not such a success and I found myself disappointment when I was finally able to see Nematodes under the microscope. I had anticipated that the movements of the Nematode would be much more thrilling and exciting, but this was not the case, I was left rather under-whelmed.
But at this moment of dissatisfaction I meet SLIME MOULD and was completely overwhelmed and excited by this very visual moving and growing cell. As a result I started to research and explore slime mould both with hands on experiments and book research.
Now my project is currently exploring the relationship between slime mould with the introduction of colour pigments both to the slime moulds food source and to its environment.
Week commencing 02/11/2020
Initial Microscope research - Week one
Research about Nematodes
- Cannibal worms recognise their children—and don’t eat them as a result
YouTube video by Science Magazine Youtube
- Meet the Most Important Animal You’ve Never Seen
Youtube video by SciShow channel Youtube
Week commencing 09/11/2020
Documentary style videos
Week commencing 16/11/2020
Movements
Nematode vs human??
Can you human body performance like a Nematode? Can the human body move like a Nematode? Can the human body become like a Nematode? Can a human move like a Nematode, is it physically possible?
SOMA - Dance Performers
As the human body is at the heart of SOMA, our dictionary of the physical movement within the performance is defined by its abilities and inabilities. We ask ourselves what the human body is capable of expressing and what are its limitations.
Nematode Movements
Examples that show the way in which Nematodes move and position themselves
Week commencing 23/11/2020
Netflix - My Octopus Teacher
Notes from watching the documentary
- There is something to learn here, something special.
- He totally mapped the octopuses environment to learn from her
- There was total trust between the octopus and him
- He almost became the octopus, he was obsessed
- The octopus taught him to become sensitised to the other
- Our lives were mirroring each others
- The octopus sacrifices her own life for her young
- In my mind I think like an octopus
- That is there strategy - live fast die young
- The octopus showed me just how precious the wild places are
Week commencing 30/11/2020
First tests with the phone microscope
Week commencing 01/12/2020
Making a medium for the Nematode
I found a DIY recipe to make an agar plate to hopefully awaken the Nematodes
Making my own Growth Medium
Ingredients for the recipe
- 0.5g Peptone
- 0.3g Yeast
- 1.5g Agar
- 0.5g Salt
- 120ml Water
Reflections
Sadly, I don't think that my medium recipe contained enough Agar because the solution didn't solidify, it remained a kind of liquid solution.
How to improve the recipe - add more agar to the recipe?
2nd Attempt to make Medium
Reflections
Because the previous recipe didn't solidify, for this recipe I added 0.5g more Agar to the mixture and then heated up the solution and poured it back into the petri dishes to then store in the fridge again. Hopefully this time the solution will solidify.
Can you see the Nematodes?
Are the Nematodes alive in the agar I created? Are they swimming or sleeping?
Reflections
After cooling the Agar in the fridge I waited 1 hour before emptying my Nematodes into the 5 different petri-dishes. I checked on them on an hourly basis to see if they were waking up and moving...Sadly I don't think they are alive. There was no movement. After 2 days the agar seemed to separate, it became very liquidy and a kind of kind grew over the top of the Agar. I don't think my agar recipe worked
After a few days my medium solution had separated, I don't think I created the correct ratio of the ingredients
Moving nematodes - pocket microscope
After sourcing some more Nematodes I used the pocket microscope to see if I could see them moving, and yes they were moving, however it was really difficult to keep the pocket microscope still so I plan to vie them under the microscope in the lab so that I have more control.
To view the videos larger I have uploaded them to YouTube
Week commencing 14/12/2021
WOW I found out about slime mould
Youtube video by the BBC about the importance of slime mould in our woodlands Youtube
- Relentless shape shifting goo
- It eats anything that gets in it's path
- Essential service in cleaning up our woodlands
- White fungus is it's pray
- When all food is gone the slime mould co-operates with itself to mass produce
- It's not a plant, animal or fungus, just one giant cell
- Moves 1cm an hour
- The whole thing is a network
- Slime mould can learn about it's surroundings
Trying to revive some dried slime mould
I will now wait 1 hour in the hope that the slime mould is becoming hydrated and will eat the oats!
After 3 days the slime mould didn't revive itself, so I will source some more slime mould!
Week commencing 21/12/2020
Cultivating slime mould
Looking under the Microscope
Using both the phone extension microscope, the pocket microscope and the Lab microscope
Week commencing 28/12/2020
Crossing borders with slime mould
Over the Christmas break me and my slime mould went on a journey back to the UK
Here you can see I tried to revive my slime mould, I bought Petri dishes and Agar to make the right environment for the slime mould but as you can see the slime mould didn't grow.
I wanted to wait a few more days to see if the slime mould would be able to grow, therefore I gave each Petri dish some more oat flakes to entice the slime mould to feed but it was unsuccessful and the more days I waited for the slime mould to grow the more I began to die and go mouldy to the point where I had to throw away all the Agar dishes because they were very contaminated with mould.
Week commencing 04/01/2021
Plans for slime mould progression
-Working with coloured Slime mould?
I began to explore how I could finalise all my research and come up with a final outcome so I stared to reflect on the work I had done and also look for visual inspiration.
- Inspiration one
I liked this digital manipulation of slime mould because of the variety of colours that were achieved.

- Inspiration two
"Suzie, the Amazing Color Changing Slime Mold" - Slime mould that has been modified to be able to change colour!
- Inspiration three
How to dye slime mould?? "Hunter encouraged Physarum growth on silk and cotton in order to obtain a vibrant yellow fabric dye that was deposited by the movement of the plasmodium over the cloth, and also observed her other cultures bridging across agar to connect two ends of silver conductive thread together. She and Matheson dyed agar and oats with food colouring, and obtained stunning photographs of the Physarum's colour uptake and visible changes when presented with the altered media."
- Inspiration four
Dying fabrics with Slime mould pigment
Website link to Open Cell research - Dye with the Slime by Piero D'Angelo [1]
- Inspiration five
Exploring the invisible - Colour (Prey) Preference in the Slime Mould Physarum polycephalum Weblink to the research page visualising the process [2]
Week Commencing 11/01/2021
Next steps
- Re-growing my slime mould when returning to Weimar, Introduce dying the Agar and the oats with food colouring to see if the slime mould changes colour as it eats this find source.
- Buy an XXXXL Petri dish so that I can grow a large surface area of slime mould.
- Exploring Zine ideas to create a slime mould zine
Zine Inspiration Research
Websites full of inspiration zines
All images are screenshots from the sources listed above
Week commencing 18/01/21
Dying experiments
Experimenting with dying the slime moulds environment. Will the slime mould adapt to it's environment and change colour also???
Process of dying the Agar
Clear agar with slime mould rapidly growing used incase the coloured slime mould didn't grow
Green dyed Agar and successfully growing slime mould
Red dyed agar and successfully growing slime mould
Blue dyed agar and successfully growing slime mould. Here you can also see that the slime mould is starting to change blue as a result of living within the blue environment.
Yellow dyed agar
Looking at the slime mould through the phone microscope
Looking at the slime mould with a DIY light under the petri-dish
Scanning experiments
Using a portable scanner I played around with the composition, colour and "glitchiness" of the results to create interesting manipulations.
- Error creating thumbnail: convert convert: Corrupt JPEG data: 12358 extraneous bytes before marker 0xd2 (/var/www/www.uni-weimar.de/kunst-und-gestaltung/wiki/public/images/IMAG0006.JPG). Error code: 1
- Error creating thumbnail: convert convert: Corrupt JPEG data: 12325 extraneous bytes before marker 0xd3 (/var/www/www.uni-weimar.de/kunst-und-gestaltung/wiki/public/images/IMAG0007.JPG). Error code: 1
- Error creating thumbnail: convert convert: Corrupt JPEG data: 11915 extraneous bytes before marker 0xd0 (/var/www/www.uni-weimar.de/kunst-und-gestaltung/wiki/public/images/IMAG0008.JPG). Error code: 1
- Error creating thumbnail: convert convert: Corrupt JPEG data: 11827 extraneous bytes before marker 0xd7 (/var/www/www.uni-weimar.de/kunst-und-gestaltung/wiki/public/images/IMAG0009.JPG). Error code: 1
- Error creating thumbnail: convert convert: Corrupt JPEG data: 2306 extraneous bytes before marker 0xd7 (/var/www/www.uni-weimar.de/kunst-und-gestaltung/wiki/public/images/IMAG0010.JPG). Error code: 1
- Error creating thumbnail: convert convert: Corrupt JPEG data: 2651 extraneous bytes before marker 0xd5 (/var/www/www.uni-weimar.de/kunst-und-gestaltung/wiki/public/images/IMAG0011.JPG). Error code: 1
- Error creating thumbnail: convert convert: Corrupt JPEG data: 2746 extraneous bytes before marker 0xd7 (/var/www/www.uni-weimar.de/kunst-und-gestaltung/wiki/public/images/IMAG0012.JPG). Error code: 1
- Error creating thumbnail: convert convert: Corrupt JPEG data: 2376 extraneous bytes before marker 0xd5 (/var/www/www.uni-weimar.de/kunst-und-gestaltung/wiki/public/images/IMAG0013.JPG). Error code: 1
- Error creating thumbnail: convert convert: Corrupt JPEG data: 2350 extraneous bytes before marker 0xd1 (/var/www/www.uni-weimar.de/kunst-und-gestaltung/wiki/public/images/IMAG0014.JPG). Error code: 1
- Error creating thumbnail: convert convert: Corrupt JPEG data: 2394 extraneous bytes before marker 0xd3 (/var/www/www.uni-weimar.de/kunst-und-gestaltung/wiki/public/images/IMAG0015.JPG). Error code: 1
- Error creating thumbnail: convert convert: Corrupt JPEG data: 2438 extraneous bytes before marker 0xd3 (/var/www/www.uni-weimar.de/kunst-und-gestaltung/wiki/public/images/IMAG0016.JPG). Error code: 1
- Error creating thumbnail: convert convert: Corrupt JPEG data: 2360 extraneous bytes before marker 0xd5 (/var/www/www.uni-weimar.de/kunst-und-gestaltung/wiki/public/images/IMAG0017.JPG). Error code: 1
- Error creating thumbnail: convert convert: Corrupt JPEG data: 2387 extraneous bytes before marker 0xd5 (/var/www/www.uni-weimar.de/kunst-und-gestaltung/wiki/public/images/IMAG0018.JPG). Error code: 1
- Error creating thumbnail: convert convert: Corrupt JPEG data: 7606 extraneous bytes before marker 0xd7 (/var/www/www.uni-weimar.de/kunst-und-gestaltung/wiki/public/images/IMAG0019.JPG). Error code: 1
- Error creating thumbnail: convert convert: Corrupt JPEG data: 7341 extraneous bytes before marker 0xd7 (/var/www/www.uni-weimar.de/kunst-und-gestaltung/wiki/public/images/IMAG0020.JPG). Error code: 1
- Error creating thumbnail: convert convert: Corrupt JPEG data: 7436 extraneous bytes before marker 0xd1 (/var/www/www.uni-weimar.de/kunst-und-gestaltung/wiki/public/images/IMAG0021.JPG). Error code: 1
- Error creating thumbnail: convert convert: Corrupt JPEG data: 7903 extraneous bytes before marker 0xd7 (/var/www/www.uni-weimar.de/kunst-und-gestaltung/wiki/public/images/IMAG0022.JPG). Error code: 1
- Error creating thumbnail: convert convert: Corrupt JPEG data: 11386 extraneous bytes before marker 0xd3 (/var/www/www.uni-weimar.de/kunst-und-gestaltung/wiki/public/images/IMAG0023.JPG). Error code: 1
- Error creating thumbnail: convert convert: Corrupt JPEG data: 8186 extraneous bytes before marker 0xd6 (/var/www/www.uni-weimar.de/kunst-und-gestaltung/wiki/public/images/IMAG0024.JPG). Error code: 1
- Error creating thumbnail: convert convert: Corrupt JPEG data: 7726 extraneous bytes before marker 0xd4 (/var/www/www.uni-weimar.de/kunst-und-gestaltung/wiki/public/images/IMAG0025.JPG). Error code: 1
- Error creating thumbnail: convert convert: Corrupt JPEG data: 7890 extraneous bytes before marker 0xd3 (/var/www/www.uni-weimar.de/kunst-und-gestaltung/wiki/public/images/IMAG0026.JPG). Error code: 1
- Error creating thumbnail: convert convert: Corrupt JPEG data: 7482 extraneous bytes before marker 0xd1 (/var/www/www.uni-weimar.de/kunst-und-gestaltung/wiki/public/images/IMAG0027.JPG). Error code: 1
- Error creating thumbnail: convert convert: Corrupt JPEG data: 7253 extraneous bytes before marker 0xd3 (/var/www/www.uni-weimar.de/kunst-und-gestaltung/wiki/public/images/IMAG0028.JPG). Error code: 1
- Error creating thumbnail: convert convert: Corrupt JPEG data: 2525 extraneous bytes before marker 0xd3 (/var/www/www.uni-weimar.de/kunst-und-gestaltung/wiki/public/images/IMAG0029.JPG). Error code: 1
- Error creating thumbnail: convert convert: Corrupt JPEG data: 2497 extraneous bytes before marker 0xd5 (/var/www/www.uni-weimar.de/kunst-und-gestaltung/wiki/public/images/IMAG0030.JPG). Error code: 1
- Error creating thumbnail: convert convert: Corrupt JPEG data: 2498 extraneous bytes before marker 0xd3 (/var/www/www.uni-weimar.de/kunst-und-gestaltung/wiki/public/images/IMAG0031.JPG). Error code: 1
- Error creating thumbnail: convert convert: Corrupt JPEG data: 3686 extraneous bytes before marker 0xd3 (/var/www/www.uni-weimar.de/kunst-und-gestaltung/wiki/public/images/IMAG0032.JPG). Error code: 1
- Error creating thumbnail: convert convert: Corrupt JPEG data: 2405 extraneous bytes before marker 0xd3 (/var/www/www.uni-weimar.de/kunst-und-gestaltung/wiki/public/images/IMAG0033.JPG). Error code: 1
- Error creating thumbnail: convert convert: Corrupt JPEG data: 11849 extraneous bytes before marker 0xd6 (/var/www/www.uni-weimar.de/kunst-und-gestaltung/wiki/public/images/IMAG0034.JPG). Error code: 1
- Error creating thumbnail: convert convert: Corrupt JPEG data: 7295 extraneous bytes before marker 0xd4 (/var/www/www.uni-weimar.de/kunst-und-gestaltung/wiki/public/images/IMAG0035.JPG). Error code: 1
- Error creating thumbnail: convert convert: Corrupt JPEG data: 12098 extraneous bytes before marker 0xd0 (/var/www/www.uni-weimar.de/kunst-und-gestaltung/wiki/public/images/IMAG0036.JPG). Error code: 1
- Error creating thumbnail: convert convert: Corrupt JPEG data: 12415 extraneous bytes before marker 0xd5 (/var/www/www.uni-weimar.de/kunst-und-gestaltung/wiki/public/images/IMAG0037.JPG). Error code: 1
- Error creating thumbnail: convert convert: Corrupt JPEG data: 11842 extraneous bytes before marker 0xd7 (/var/www/www.uni-weimar.de/kunst-und-gestaltung/wiki/public/images/IMAG0038.JPG). Error code: 1
- Error creating thumbnail: convert convert: Corrupt JPEG data: 11925 extraneous bytes before marker 0xd0 (/var/www/www.uni-weimar.de/kunst-und-gestaltung/wiki/public/images/IMAG0039.JPG). Error code: 1
- Error creating thumbnail: convert convert: Corrupt JPEG data: 11981 extraneous bytes before marker 0xd1 (/var/www/www.uni-weimar.de/kunst-und-gestaltung/wiki/public/images/IMAG0040.JPG). Error code: 1
- Error creating thumbnail: convert convert: Corrupt JPEG data: 11945 extraneous bytes before marker 0xd2 (/var/www/www.uni-weimar.de/kunst-und-gestaltung/wiki/public/images/IMAG0041.JPG). Error code: 1
- Error creating thumbnail: convert convert: Corrupt JPEG data: 11920 extraneous bytes before marker 0xd7 (/var/www/www.uni-weimar.de/kunst-und-gestaltung/wiki/public/images/IMAG0042.JPG). Error code: 1
- Error creating thumbnail: convert convert: Corrupt JPEG data: 11817 extraneous bytes before marker 0xd5 (/var/www/www.uni-weimar.de/kunst-und-gestaltung/wiki/public/images/IMAG0043.JPG). Error code: 1
- Error creating thumbnail: convert convert: Corrupt JPEG data: 9270 extraneous bytes before marker 0xd2 (/var/www/www.uni-weimar.de/kunst-und-gestaltung/wiki/public/images/IMAG0044.JPG). Error code: 1
- Error creating thumbnail: convert convert: Corrupt JPEG data: 9979 extraneous bytes before marker 0xd5 (/var/www/www.uni-weimar.de/kunst-und-gestaltung/wiki/public/images/IMAG0045.JPG). Error code: 1
- Error creating thumbnail: convert convert: Corrupt JPEG data: 11734 extraneous bytes before marker 0xd4 (/var/www/www.uni-weimar.de/kunst-und-gestaltung/wiki/public/images/IMAG0046.JPG). Error code: 1
- Error creating thumbnail: convert convert: Corrupt JPEG data: 10832 extraneous bytes before marker 0xd3 (/var/www/www.uni-weimar.de/kunst-und-gestaltung/wiki/public/images/IMAG0047.JPG). Error code: 1
- Error creating thumbnail: convert convert: Corrupt JPEG data: 8341 extraneous bytes before marker 0xd4 (/var/www/www.uni-weimar.de/kunst-und-gestaltung/wiki/public/images/IMAG0048.JPG). Error code: 1
- Error creating thumbnail: convert convert: Corrupt JPEG data: 11742 extraneous bytes before marker 0xd0 (/var/www/www.uni-weimar.de/kunst-und-gestaltung/wiki/public/images/IMAG0049.JPG). Error code: 1
- Error creating thumbnail: convert convert: Corrupt JPEG data: 8599 extraneous bytes before marker 0xd3 (/var/www/www.uni-weimar.de/kunst-und-gestaltung/wiki/public/images/IMAG0050.JPG). Error code: 1
- Error creating thumbnail: convert convert: Corrupt JPEG data: 11729 extraneous bytes before marker 0xd0 (/var/www/www.uni-weimar.de/kunst-und-gestaltung/wiki/public/images/IMAG0051.JPG). Error code: 1
- Error creating thumbnail: convert convert: Corrupt JPEG data: 7618 extraneous bytes before marker 0xd6 (/var/www/www.uni-weimar.de/kunst-und-gestaltung/wiki/public/images/IMAG0052.JPG). Error code: 1
- Error creating thumbnail: convert convert: Corrupt JPEG data: 7525 extraneous bytes before marker 0xd6 (/var/www/www.uni-weimar.de/kunst-und-gestaltung/wiki/public/images/IMAG0053.JPG). Error code: 1
- Error creating thumbnail: convert convert: Corrupt JPEG data: 10159 extraneous bytes before marker 0xd0 (/var/www/www.uni-weimar.de/kunst-und-gestaltung/wiki/public/images/IMAG0054.JPG). Error code: 1
- Error creating thumbnail: convert convert: Corrupt JPEG data: 7289 extraneous bytes before marker 0xd0 (/var/www/www.uni-weimar.de/kunst-und-gestaltung/wiki/public/images/IMAG0055.JPG). Error code: 1
- Error creating thumbnail: convert convert: Corrupt JPEG data: 7521 extraneous bytes before marker 0xd5 (/var/www/www.uni-weimar.de/kunst-und-gestaltung/wiki/public/images/IMAG0056.JPG). Error code: 1
- Error creating thumbnail: convert convert: Corrupt JPEG data: 3016 extraneous bytes before marker 0xd7 (/var/www/www.uni-weimar.de/kunst-und-gestaltung/wiki/public/images/IMAG0057.JPG). Error code: 1
- Error creating thumbnail: convert convert: Corrupt JPEG data: 3042 extraneous bytes before marker 0xd7 (/var/www/www.uni-weimar.de/kunst-und-gestaltung/wiki/public/images/IMAG0058.JPG). Error code: 1
- Error creating thumbnail: convert convert: Corrupt JPEG data: 2467 extraneous bytes before marker 0xd1 (/var/www/www.uni-weimar.de/kunst-und-gestaltung/wiki/public/images/IMAG0059.JPG). Error code: 1
- Error creating thumbnail: convert convert: Corrupt JPEG data: 3781 extraneous bytes before marker 0xd3 (/var/www/www.uni-weimar.de/kunst-und-gestaltung/wiki/public/images/IMAG0060.JPG). Error code: 1
- Error creating thumbnail: convert convert: Corrupt JPEG data: 2571 extraneous bytes before marker 0xd5 (/var/www/www.uni-weimar.de/kunst-und-gestaltung/wiki/public/images/IMAG0061.JPG). Error code: 1
- Error creating thumbnail: convert convert: Corrupt JPEG data: 7767 extraneous bytes before marker 0xd4 (/var/www/www.uni-weimar.de/kunst-und-gestaltung/wiki/public/images/IMAG0062.JPG). Error code: 1
Slime mould narrative for the Zine publication
Border of slime mould
Week commencing 25/01/21
Clear Agar with slime growing
Green Slime mould growing
Red slime mould growing
Blue slime mould growing
Yellow slime mould growing
Developed plan for the zine
Why did I chose to work with slime mould?
Because when I discovered it I was so interested by this micro-organism that was growing before my eyes! It was something so visual that I felt captivated and intrigued by it. Because of this the narrative of my zine will be about the discovery of slime mould.
Zine narrative - Discovery of slime mould
Zine will include
- My initial images of visualising slime mould
- My colour dying Agar experiments
- Other peoples interpretations of what they think slime mould is (without knowing what it is)
- Haiku poems
- Questions
- My scanned slime mould experiments
- Analogue collaging